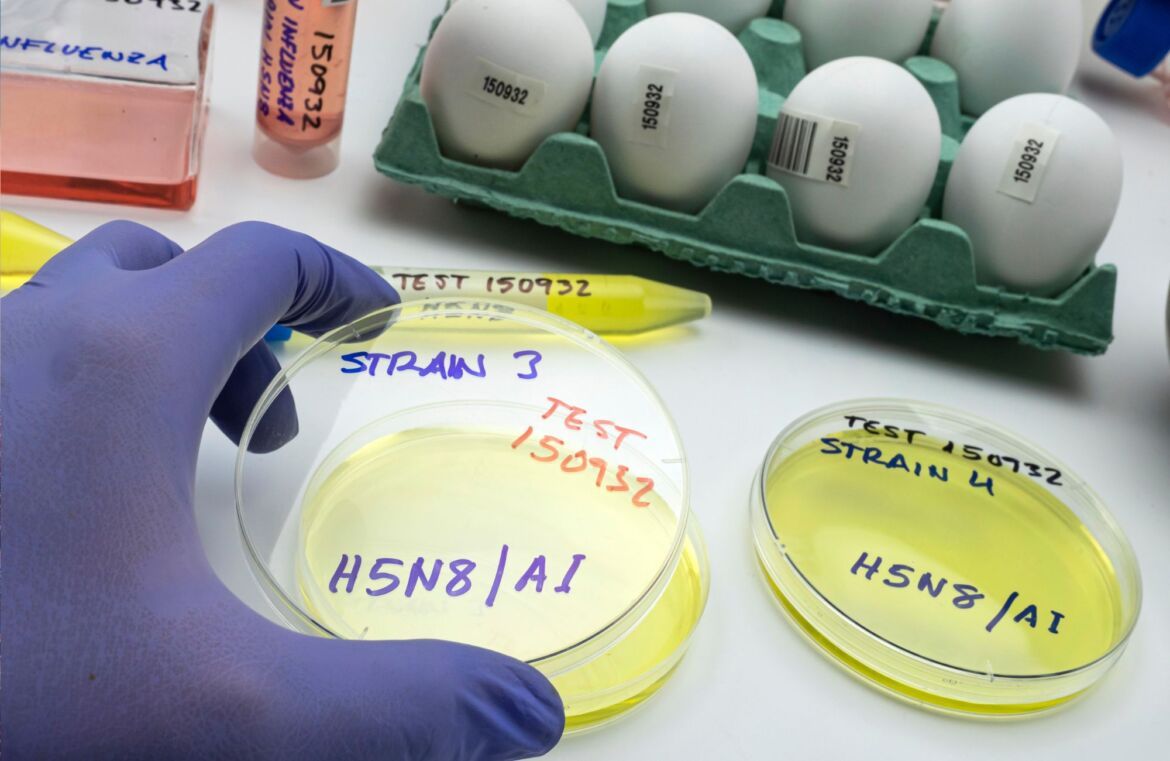

A visitação ao Parque Zoológico de Sapucaia do Sul foi suspensa por tempo indeterminado após a confirmação de casos de Influenza Aviária de Alta Patogenicidade (H5N1) em cisnes e patos. A medida foi anunciada nesta sexta-feira (16) pelo Governo do Estado, por meio da Secretaria do Meio Ambiente e Infraestrutura (Sema), após divulgação do laudo pelo Ministério da Agricultura e Pecuária (Mapa) durante coletiva de imprensa.
O acesso do público já estava suspenso de forma preventiva desde a quarta-feira (14), enquanto eram analisadas amostras dos animais mortos. Segundo a Sema, os trabalhos internos de atendimento aos demais animais continuam normalmente.
Doença exige atenção e notificação imediata
A Influenza Aviária, conhecida como gripe aviária, é uma doença viral altamente contagiosa que atinge principalmente aves silvestres e domésticas, mas também pode infectar seres humanos. Os principais sintomas nas aves incluem dificuldade respiratória, secreção nasal ou ocular, espirros, falta de coordenação motora, torcicolo, diarreia e alta mortalidade.
A Sema orienta que todas as suspeitas de Influenza Aviária sejam notificadas imediatamente à Secretaria da Agricultura, por meio da Inspetoria de Defesa Agropecuária mais próxima ou pelo WhatsApp (51) 98445-2033.